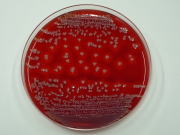

細菌検査室
細菌検査とは
発熱、腫れ、下痢などの症状があり、細菌による感染症が疑われる場合に、その原因となっている菌を見つけ出し、どのような薬剤が有効か調べる検査です。喀痰、尿、便、血液、膿など、様々なものが検査材料になります。細菌検査にかかる日数は通常3~4日ですが、発育が遅い菌や培養が困難な菌などの場合、さらに日数がかかります。 またインフルエンザウイルスやアデノウイルスなどのウイルスに感染しているかを調べる迅速検査も行っています。
検査について
顕微鏡検査
ガラス板に検査材料を塗りつけ、染色を行い、菌の有無、色、形態などを顕微鏡で観察します。
|
顕微鏡 |
黄色ブドウ球菌 |
アスペルギルス |
培養・同定検査
培養
検査材料を目的とする菌や発育が予想される菌に合わせて、数種類の培地に塗って培養します。培地には、菌が発育するのに必要な栄養や、目的菌以外の菌の発育を抑える成分などが含まれています。培養すると菌は増殖して集落と呼ばれる塊を作り、肉眼で見られる大きさになります。
同定
発育してきた菌の集落の色、形態、発育した培地などから菌名を突き止めます。
|
様々な培地 |
黄色ブドウ球菌の集落 |
血液培養装置 |
薬剤感受性検査
検出された菌を何種類かの薬剤と一緒に培養し、どの薬剤で菌の発育が抑えられているかを検査し、検出された菌に有効な薬剤を調べます。
|
薬剤感受性判定装置 |
使用プレート |
検査例 使用薬剤12種 |
迅速検査
一部のウイルスや細菌は、培養を行わず、専用のキットを使用し、検査材料から直接抗原を検出することで、感染の有無を直接調べることができます。検査時間は20分程度です。
検査できるウイルス
| インフルエンザウイルス | 冬期に流行するインフルエンザの原因となるウイルス A型・B型の判別が可能 |
|---|---|
| アデノウイルス | 小児の急性熱性咽頭炎、咽頭結膜炎などの原因となるウイルス |
| RSウイルス | 乳幼児の肺炎、気管支炎の原因となるウイルス |
| ロタウイルス | 冬期の乳幼児下痢症の原因となるウイルス |
検査できる細菌
| A群溶血レンサ球菌 | 小児の急性咽頭炎、急性扁桃炎などの原因となる細菌 また、劇症型溶血性連鎖球菌感染症の原因となる細菌 |
|---|---|
| 肺炎球菌・レジオネラ菌 | 肺炎を引き起こす原因となる細菌 |
|
インフルエンザ検査例 |
インフルエンザ判定 陰性例 |
アデノ判定 陽性例 |
院内感染対策
ICT(院内感染対策チーム)の一員として、院内感染防止のため、月毎に各種検査材料からの細菌の検出状況や薬剤感受性パターンの調査・報告を行っています。また、給水設備や院内で調製しているミルクの定期的な細菌検査、器具や環境の汚染状況の検査など、院内の環境検査を行っています。 そして職員が感染症に対する知識を深められるように、世間で話題になっている感染症を主に取り上げた職員向けの情報誌の発行も行っています。